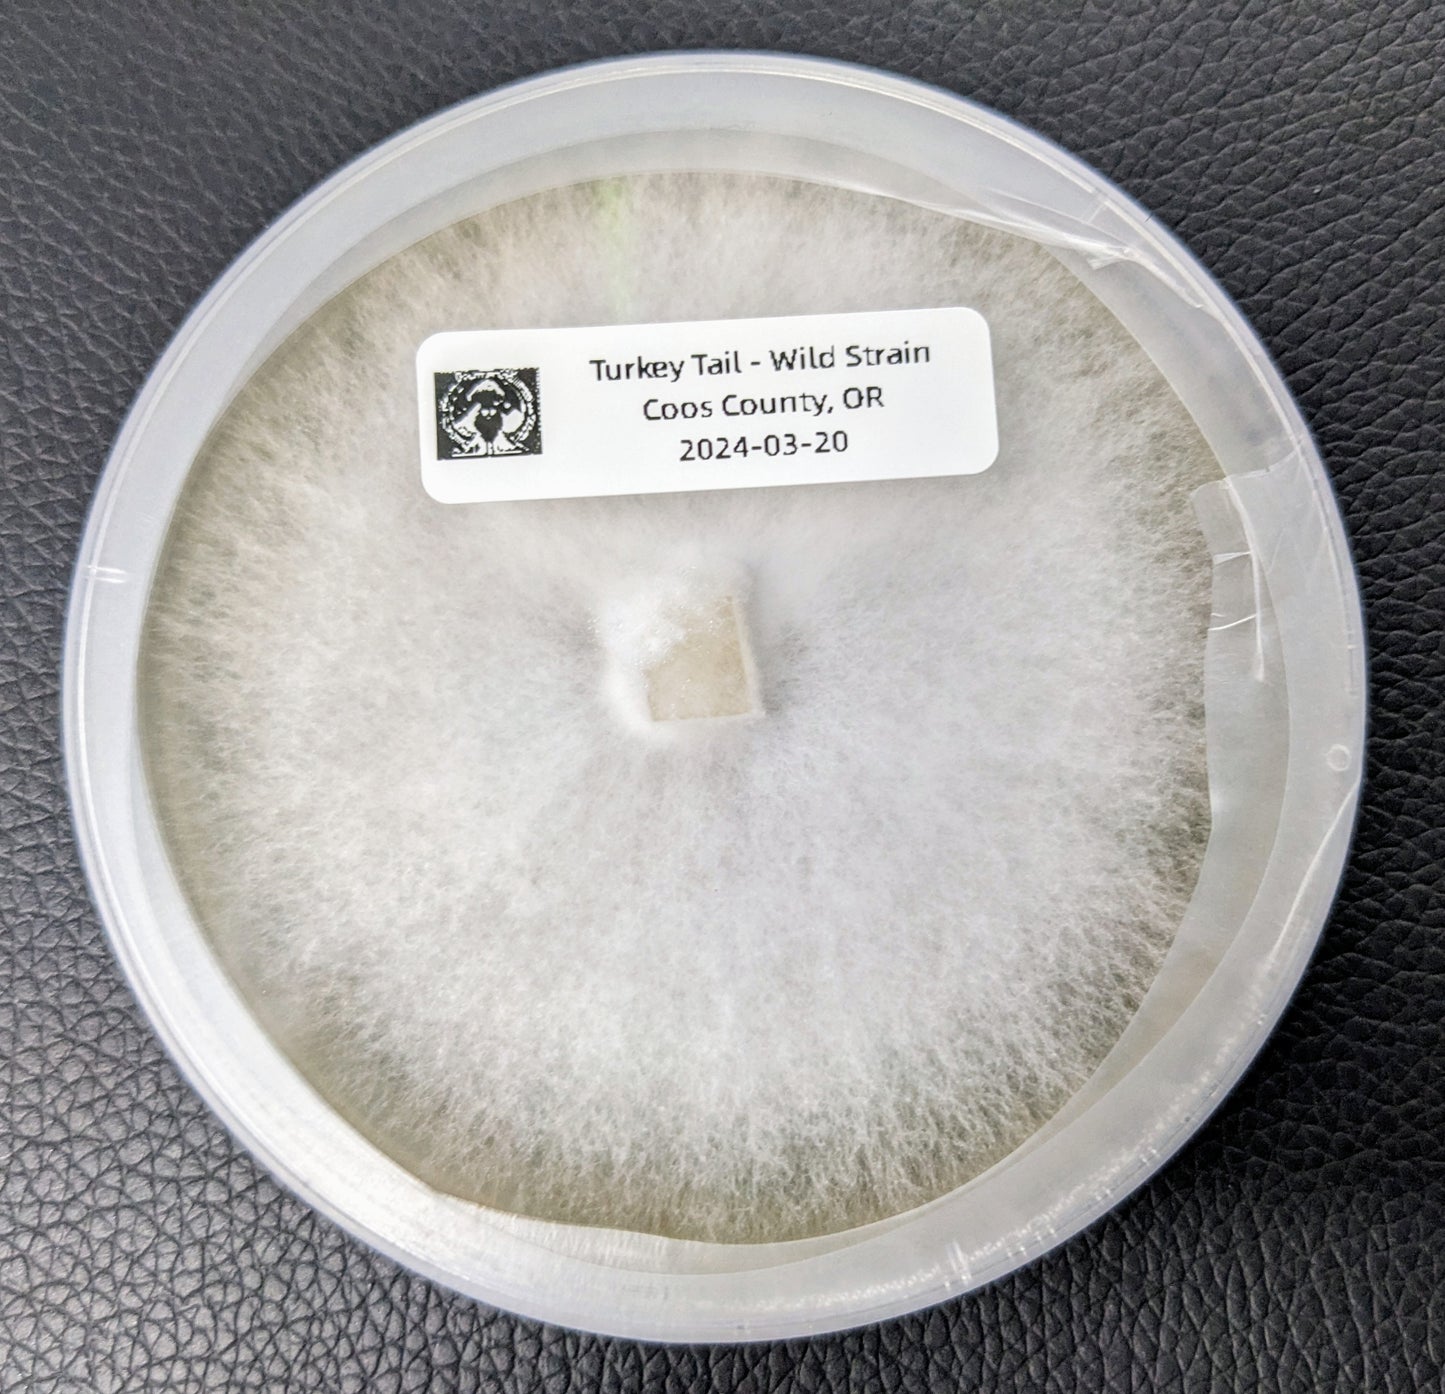

1
/
of
2
Gourmet Gills
South Slough Turkey Tail - Agar Plate
South Slough Turkey Tail - Agar Plate
Regular price
$15.00 USD
Regular price
$15.00 USD
Sale price
$15.00 USD
Unit price
/
per
Couldn't load pickup availability
Trametes versicolor
This is a wild strain that I found while hiking down at the South Slough, in Charleston, OR. The mycelium is very vigorous and will fully colonize grain and sawdust in about 10-14 days. It's pretty slow to fruit. I've found they fruit better outdoors than in my high humidity fruiting chamber. At least, here on the coast.
No reviews